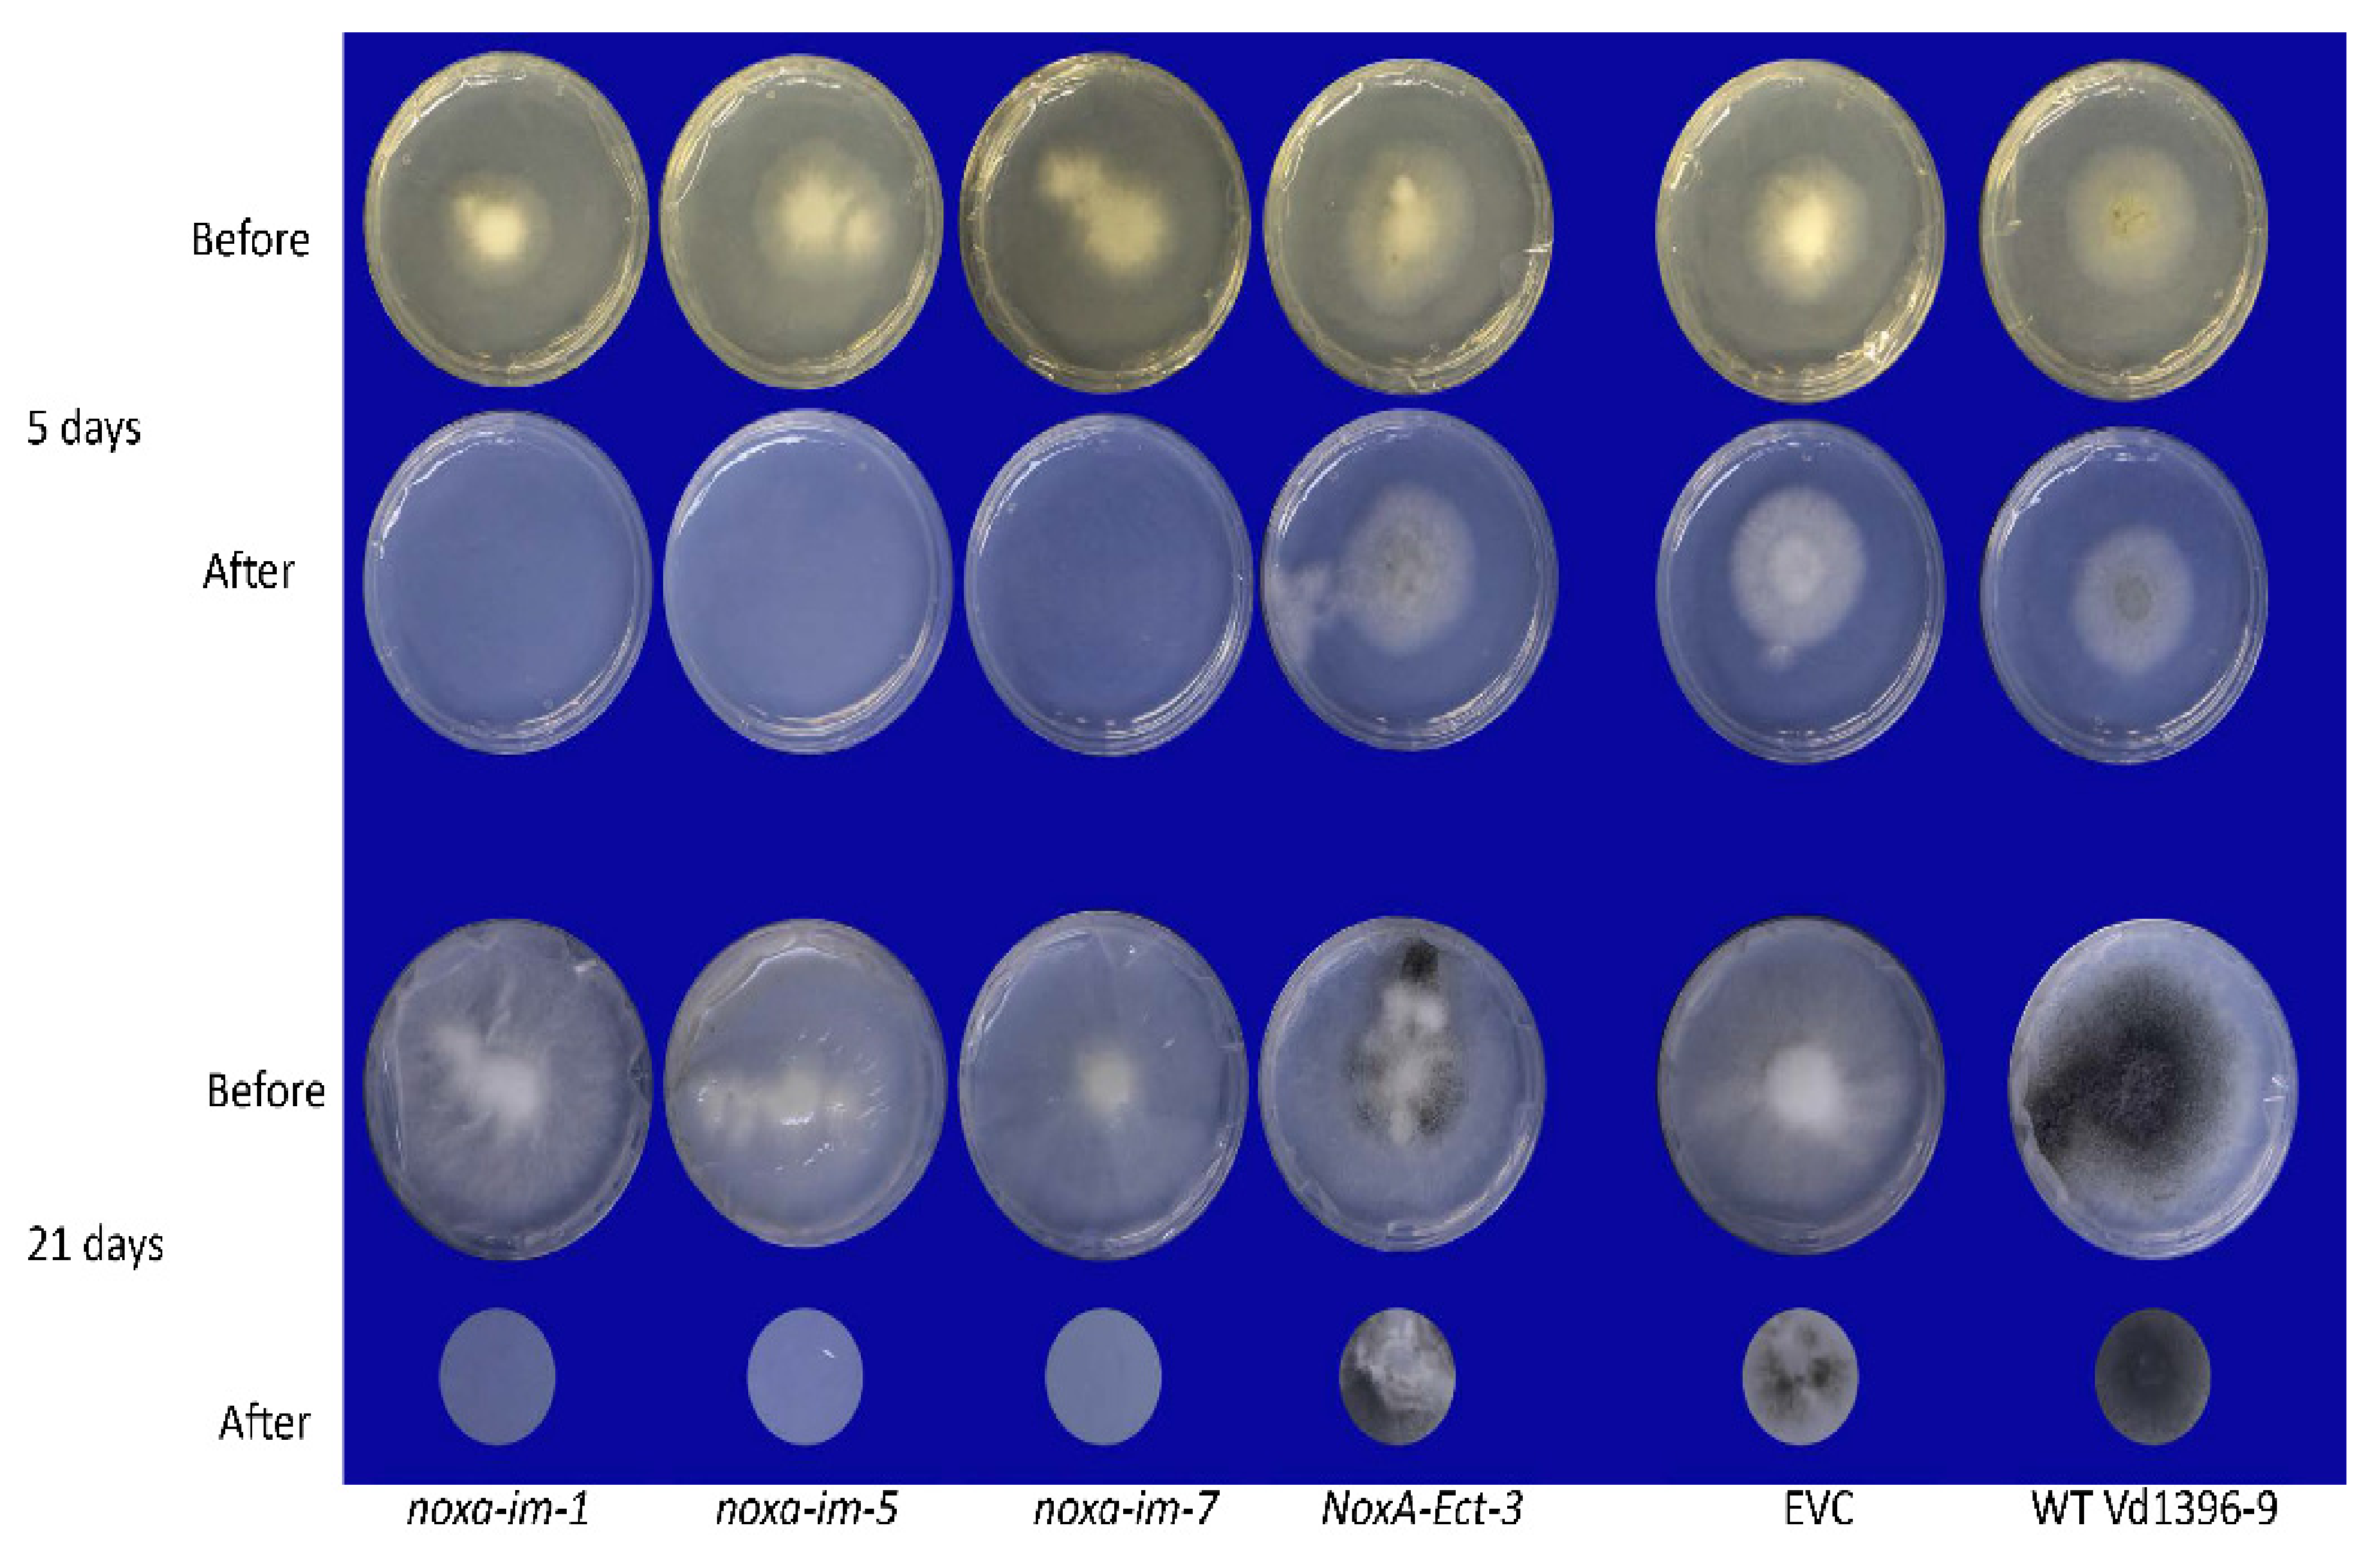
Jof 07 00814 g007

NOXA Is Important for Verticillium dahliae’s Penetration Ability and Virulence
Abstract
1. Introduction
2. Materials and Methods
2.1. V. dahliae Isolates and Plant Materials
2.2. NoxA Genes Expression in Response to Infection and During Elicitation with Potato Tissue Extracts
2.3. Gene Disruption and Complementation of V. dahliae
2.4. Growth Rate and Conidiation of Noxa Mutants
2.5. The Pathogenicity Analysis of Noxa Mutants and Noxa Complementation Strain
2.6. Cell Wall Biosynthesis and Response to Stress Conditions
2.7. Penetration and Germination Abilities of Noxa Mutants on Cellophane Membrane
2.8. Formation of Conidiophores of Noxa Mutants
2.9. Statistical Analysis
3. Results
3.1. Expression of NoxA Gene in V. dahliae in Response to Potato Extracts and Infection
3.2. Generation of Gene Insertion Mutants for NoxA Family Member and Transformant Complemented with Full Length NoxA Genes
3.3. Growth Rate and Conidiation of Noxa Mutants
3.4. The Pathogenicity Analysis of Noxa Mutants and Noxa Complementation Strain
3.5. Cell Wall Biosynthesis
3.6. Resistance to Oxidative Stress and Osmotic Stress
3.7. The Penetration, Germination Ability as Well as Conidiophore Formation of the Noxa Mutants and Complemented Mutants
4. Discussion
5. Conclusions
Supplementary Materials
Author Contributions
Funding
Institutional Review Board Statement
Informed Consent Statement
Data Availability Statement
Acknowledgments
Conflicts of Interest
References
- Powelson, M.L.; Rowe, R.C. Biology and management of early dying of potatoes. Annu. Rev. Phytopathol. 1993, 31, 111–126. [Google Scholar] [CrossRef]
- Cappaert, M.; Powelson, M.; Christensen, N.; Crowe, F. Influence of irrigation on severity of potato early dying and tuber yield. Phytopathology 1992, 82, 1448–1453. [Google Scholar] [CrossRef]
- Davis, J. Verticillium wilt of potato in southwestern Idaho. Univ. Ida. Curr. Inf. Ser. 1981, 564, 3. [Google Scholar]
- Nnodu, E.; Harrison, M. The relationship between Verticillium albo-atrum inoculum density and potato yield. Am. J. Potato Res. 1979, 56, 11–25. [Google Scholar] [CrossRef]
- Barbara, D.J.; Clewes, E. Plant pathogenic Verticillium species: How many of them are there? Mol. Plant Pathol. 2003, 4, 297–305. [Google Scholar] [CrossRef] [PubMed]
- Pegg, G.F.; Brady, B.L. Verticillium Wilts; CABI: Wallingford, UK, 2002. [Google Scholar]
- Rowe, R.C.; Powelson, M.L. Potato early dying: Management challenges in a changing production environment. Plant Dis. 2002, 86, 1184–1193. [Google Scholar] [CrossRef]
- Wilhelm, S. Longevity of the Verticillium wilt fungus in the laboratory and field. Phytopathology 1955, 45, 180–181. [Google Scholar]
- Martin, M.; Riedel, R.; Rowe, R. Verticillium dahliae and Pratylenchus penetrans: Interactions in the Early Dying Complex of Potato in Ohio. Phytopathology 1982, 72, 640–644. [Google Scholar] [CrossRef]
- Hanmer, D.R. Verticillium Dahliae and Pratylenchus Penetrans Interaction on Processing Tomatoes. Ph.D. Thesis, The Ohio State University, Columbus, OH, USA, 1995. [Google Scholar]
- Bowers, J.; Nameth, S.; Riedel, R.; Rowe, R. Infection and colonization of potato roots by Verticillium dahliae as affected by Pratylenchus penetrans and P. crenatus. Phytopathology 1996, 86, 614–621. [Google Scholar] [CrossRef]
- Molina, O.I.; Tenuta, M.; El Hadrami, A.; Buckley, K.; Cavers, C.; Daayf, F. Potato early dying and yield responses to compost, green manures, seed meal and chemical treatments. Am. J. Potato Res. 2014, 91, 414–428. [Google Scholar] [CrossRef]
- An, Z.-Q.; Hendrix, J.; Hershman, D.; Ferriss, R.; Henson, G. The influence of crop rotation and soil fumigation on a mycorrhizal fungal community associated with soybean. Mycorrhiza 1993, 3, 171–182. [Google Scholar] [CrossRef]
- Havlin, J.; Kissel, D.; Maddux, L.; Claassen, M.; Long, J. Crop rotation and tillage effects on soil organic carbon and nitrogen. Soil Sci. Soc. Am. J. 1990, 54, 448–452. [Google Scholar] [CrossRef]
- Lupwayi, N.; Rice, W.; Clayton, G. Soil microbial diversity and community structure under wheat as influenced by tillage and crop rotation. Soil Biol. Biochem. 1998, 30, 1733–1741. [Google Scholar] [CrossRef]
- Martin-Rueda, I.; Munoz-Guerra, L.; Yunta, F.; Esteban, E.; Tenorio, J.; Lucena, J. Tillage and crop rotation effects on barley yield and soil nutrients on a Calciortidic Haploxeralf. Soil Tillage Res. 2007, 92, 1–9. [Google Scholar] [CrossRef]
- Erbs, M.; Manderscheid, R.; Jansen, G.; Seddig, S.; Pacholski, A.; Weigel, H.-J. Effects of free-air CO2 enrichment and nitrogen supply on grain quality parameters and elemental composition of wheat and barley grown in a crop rotation. Agric. Ecosyst. Environ. 2010, 136, 59–68. [Google Scholar] [CrossRef]
- Agrios, G. Plant Pathology; Academic Press: San Diego, CA, USA, 2005. [Google Scholar]
- Bhat, R.; Subbarao, K. Host range specificity in Verticillium dahliae. Phytopathology 1999, 89, 1218–1225. [Google Scholar] [CrossRef]
- Klosterman, S.J.; Atallah, Z.K.; Vallad, G.E.; Subbarao, K.V. Diversity, pathogenicity, and management of Verticillium species. Annu. Rev. Phytopathol. 2009, 47, 39–62. [Google Scholar] [CrossRef]
- Davis, J.R.; Huisman, O.; Everson, D.O.; Nolte, P.; Sorenson, L.; Schneider, A. The suppression of Verticillium wilt of potato using corn as a green manure crop. Am. J. Potato Res. 2010, 87, 195–208. [Google Scholar] [CrossRef]
- Ochiai, N.; Powelson, M.; Crowe, F.; Dick, R. Green manure effects on soil quality in relation to suppression of Verticillium wilt of potatoes. Biol. Fertil. Soils 2008, 44, 1013–1023. [Google Scholar] [CrossRef]
- El Hadrami, A.; Adam, L.R.; El Hadrami, I.; Daayf, F. Chitosan in plant protection. Mar. Drugs 2010, 8, 968–987. [Google Scholar] [CrossRef]
- Collins, H.; Alva, A.; Boydston, R.; Cochran, R.; Hamm, P.; McGuire, A.; Riga, E. Soil microbial, fungal, and nematode responses to soil fumigation and cover crops under potato production. Biol. Fertil. Soils 2006, 42, 247–257. [Google Scholar] [CrossRef]
- Shetty, K.; Subbarao, K.; Huisman, O.; Hubbard, J. Mechanism of broccoli-mediated Verticillium wilt reduction in cauliflower. Phytopathology 2000, 90, 305–310. [Google Scholar] [CrossRef]
- Subbarao, K.V.; Kabir, Z.; Martin, F.; Koike, S. Management of soilborne diseases in strawberry using vegetable rotations. Plant Dis. 2007, 91, 964–972. [Google Scholar] [CrossRef]
- Subbarao, K.V.; Hubbard, J.C.; Koike, S.T. Evaluation of broccoli residue incorporation into field soil for Verticillium wilt control in cauliflower. Plant Dis. 1999, 83, 124–129. [Google Scholar] [CrossRef] [PubMed]
- Matthiessen, J.N.; Kirkegaard, J.A. Biofumigation and enhanced biodegradation: Opportunity and challenge in soilborne pest and disease management. Crit. Rev. Plant Sci. 2006, 25, 235–265. [Google Scholar] [CrossRef]
- Antonopoulos, D.F.; Tjamos, S.E.; Antoniou, P.P.; Rafeletos, P.; Tjamos, E.C. Effect of Paenibacillus alvei, strain K165, on the germination of Verticillium dahliae microsclerotia in planta. Biol. Control 2008, 46, 166–170. [Google Scholar] [CrossRef]
- Tjamos, E.C.; Tsitsigiannis, D.I.; Tjamos, S.E.; Antoniou, P.P.; Katinakis, P. Selection and screening of endorhizosphere bacteria from solarized soils as biocontrol agents against Verticillium dahliae of solanaceous hosts. Eur. J. Plant Pathol. 2004, 110, 35–44. [Google Scholar] [CrossRef]
- Uppal, A.; El Hadrami, A.; Adam, L.; Tenuta, M.; Daayf, F. Biological control of potato Verticillium wilt under controlled and field conditions using selected bacterial antagonists and plant extracts. Biol. Control 2008, 44, 90–100. [Google Scholar] [CrossRef]
- Daayf, F. Verticillium wilts in crop plants: Pathogen invasion and host defence responses. Can. J. Plant Pathol. 2015, 37, 8–20. [Google Scholar] [CrossRef]
- Kawchuk, L.M.; Hachey, J.; Lynch, D.R.; Kulcsar, F.; Van Rooijen, G.; Waterer, D.R.; Robertson, A.; Kokko, E.; Byers, R.; Howard, R.J. Tomato Ve disease resistance genes encode cell surface-like receptors. Proc. Natl. Acad. Sci. USA 2001, 98, 6511–6515. [Google Scholar] [CrossRef]
- Fradin, E.F.; Zhang, Z.; Ayala, J.C.J.; Castroverde, C.D.; Nazar, R.N.; Robb, J.; Liu, C.-M.; Thomma, B.P. Genetic dissection of Verticillium wilt resistance mediated by tomato Ve1. Plant Physiol. 2009, 150, 320–332. [Google Scholar] [CrossRef] [PubMed]
- Liu, S.P.; Zhu, Y.P.; Xie, C.; Jue, D.W.; Hong, Y.b.; Chen, M.; Hubdar, A.K.; Yang, Q. Transgenic potato plants expressing StoVe1 exhibit enhanced resistance to Verticillium dahliae. Plant Mol. Biol. Rep. 2012, 30, 1032–1039. [Google Scholar] [CrossRef]
- Simko, I.; Costanzo, S.; Haynes, K.; Christ, B.; Jones, R. Linkage disequilibrium mapping of a Verticillium dahliae resistance quantitative trait locus in tetraploid potato (Solanum tuberosum) through a candidate gene approach. Theor. Appl. Genet. 2004, 108, 217–224. [Google Scholar] [CrossRef] [PubMed]
- Simko, I.; Haynes, K.; Ewing, E.; Costanzo, S.; Christ, B.; Jones, R. Mapping genes for resistance to Verticillium albo-atrum in tetraploid and diploid potato populations using haplotype association tests and genetic linkage analysis. Mol. Genet. Genom. 2004, 271, 522–531. [Google Scholar] [CrossRef] [PubMed]
- Tsror, L.; Shlevin, E.; Peretz-Alon, I. Efficacy of metam sodium for controlling Verticillium dahliae prior to potato production in sandy soils. Am. J. Potato Res. 2005, 82, 419–423. [Google Scholar] [CrossRef]
- Duniway, J. Status of chemical alternatives to methyl bromide for pre-plant fumigation of soil. Phytopathology 2002, 92, 1337–1343. [Google Scholar] [CrossRef] [PubMed]
- Wilhelm, S.; Ferguson, J. Soil fumigation against Verticillium albo-atrum. Phytopathology 1953, 43, 593–596. [Google Scholar]
- Wilhelm, S.; Storkan, R.; Sagen, J. Verticillium wilt of strawberry controlled by fumigation of soil with chloropicrin and chloropicrin-methyl bromide mixtures. Phytopathology 1961, 51, 744–748. [Google Scholar]
- Davis, J.; Huisman, O.; Westermann, D.; Hafez, S.; Everson, D.; Sorensen, L.; Schneider, A. Effects of green manures on Verticillium wilt of potato. Phytopathology 1996, 86, 444–453. [Google Scholar] [CrossRef]
- Martin, F.N. Development of alternative strategies for management of soilborne pathogens currently controlled with methyl bromide. Annu. Rev. Phytopathol. 2003, 41, 325–350. [Google Scholar] [CrossRef]
- Ajwa, H.; Trout, T.; Mueller, J.; Wilhelm, S.; Nelson, S.; Soppe, R.; Shatley, D. Application of alternative fumigants through drip irrigation systems. Phytopathology 2002, 92, 1349–1355. [Google Scholar] [CrossRef]
- Giesbert, S.; Schuerg, T.; Scheele, S.; Tudzynski, P. The NADPH oxidase Cpnox1 is required for full pathogenicity of the ergot fungus Claviceps purpurea. Mol. Plant Pathol. 2008, 9, 317–327. [Google Scholar] [CrossRef]
- Rolke, Y.; Tudzynski, P. The small GTPase Rac and the p21-activated kinase Cla4 in Claviceps purpurea: Interaction and impact on polarity, development and pathogenicity. Mol. Microbiol. 2008, 68, 405–423. [Google Scholar] [CrossRef] [PubMed]
- Eaton, C.J.; Cox, M.P.; Scott, B. What triggers grass endophytes to switch from mutualism to pathogenism? Plant Sci. 2011, 180, 190–195. [Google Scholar] [CrossRef] [PubMed]
- Malagnac, F.; Lalucque, H.; Lepère, G.; Silar, P. Two NADPH oxidase isoforms are required for sexual reproduction and ascospore germination in the filamentous fungus Podospora anserina. Fungal Genet. Biol. 2004, 41, 982–997. [Google Scholar] [CrossRef]
- Kim, H.-J.; Chen, C.; Kabbage, M.; Dickman, M.B. Identification and characterization of Sclerotinia sclerotiorum NADPH oxidases. Appl. Environ. Microbiol. 2011, 77, 7721–7729. [Google Scholar] [CrossRef]
- Wang, L.; Mogg, C.; Walkowiak, S.; Joshi, M.; Subramaniam, R. Characterization of NADPH oxidase genes NoxA and NoxB in Fusarium graminearum. Can. J. Plant Pathol. 2014, 36, 12–21. [Google Scholar] [CrossRef]
- Cano-Domínguez, N.; Álvarez-Delfín, K.; Hansberg, W.; Aguirre, J. NADPH oxidases NOX-1 and NOX-2 require the regulatory subunit NOR-1 to control cell differentiation and growth in Neurospora crassa. Eukaryot. Cell 2008, 7, 1352–1361. [Google Scholar] [CrossRef]
- Zhang, C.; Lin, Y.; Wang, J.; Wang, Y.; Chen, M.; Norvienyeku, J.; Li, G.; Yu, W.; Wang, Z. FgNoxR, a regulatory subunit of NADPH oxidases, is required for female fertility and pathogenicity in Fusarium graminearum. FEMS Microbiol. Lett. 2016, 363, fnv223. [Google Scholar] [CrossRef][Green Version]
- Egan, M.J.; Wang, Z.-Y.; Jones, M.A.; Smirnoff, N.; Talbot, N.J. Generation of reactive oxygen species by fungal NADPH oxidases is required for rice blast disease. Proc. Natl. Acad. Sci. USA 2007, 104, 11772–11777. [Google Scholar] [CrossRef]
- Heller, J.; Tudzynski, P. Reactive oxygen species in phytopathogenic fungi: Signaling, development, and disease. Annu. Rev. Phytopathol. 2011, 49, 369–390. [Google Scholar] [CrossRef] [PubMed]
- Tudzynski, P.; Heller, J.; Siegmund, U. Reactive oxygen species generation in fungal development and pathogenesis. Curr. Opin. Microbiol. 2012, 15, 653–659. [Google Scholar] [CrossRef]
- Bedard, K.; Lardy, B.; Krause, K.-H. NOX family NADPH oxidases: Not just in mammals. Biochimie 2007, 89, 1107–1112. [Google Scholar] [CrossRef] [PubMed]
- Takemoto, D.; Tanaka, A.; Scott, B. NADPH oxidases in fungi: Diverse roles of reactive oxygen species in fungal cellular differentiation. Fungal Genet. Biol. 2007, 44, 1065–1076. [Google Scholar] [CrossRef] [PubMed]
- Lara-Ortíz, T.; Riveros-Rosas, H.; Aguirre, J. Reactive oxygen species generated by microbial NADPH oxidase NoxA regulate sexual development in Aspergillus nidulans. Mol. Microbiol. 2003, 50, 1241–1255. [Google Scholar] [CrossRef] [PubMed]
- Tanaka, A.; Christensen, M.J.; Takemoto, D.; Park, P.; Scott, B. Reactive oxygen species play a role in regulating a fungus–perennial ryegrass mutualistic interaction. Plant Cell 2006, 18, 1052–1066. [Google Scholar] [CrossRef]
- Lewit-Bentley, A.; Réty, S. EF-hand calcium-binding proteins. Curr. Opin. Struct. Biol. 2000, 10, 637–643. [Google Scholar] [CrossRef]
- Yang, S.L.; Chung, K.R. Similar and distinct roles of NADPH oxidase components in the tangerine pathotype of Alternaria alternata. Mol. Plant Pathol. 2013, 14, 543–556. [Google Scholar] [CrossRef]
- Segmüller, N.; Kokkelink, L.; Giesbert, S.; Odinius, D.; van Kan, J.; Tudzynski, P. NADPH oxidases are involved in differentiation and pathogenicity in Botrytis cinerea. Mol. Plant-Microbe Interact. 2008, 21, 808–819. [Google Scholar] [CrossRef]
- Zhao, Y.-L.; Zhou, T.-T.; Guo, H.-S. Hyphopodium-specific VdNoxB/VdPls1-dependent ROS-Ca2+ signaling is required for plant infection by Verticillium dahliae. PLoS Pathog. 2016, 12, e1005793. [Google Scholar] [CrossRef]
- El-Bebany, A.F.; Rampitsch, C.; Daayf, F. Proteomic analysis of the phytopathogenic soilborne fungus Verticillium dahliae reveals differential protein expression in isolates that differ in aggressiveness. Proteomics 2010, 10, 289–303. [Google Scholar] [CrossRef]
- Bazil, J.N.; Pannala, V.R.; Dash, R.K.; Beard, D.A. Determining the origins of superoxide and hydrogen peroxide in the mammalian NADH: Ubiquinone oxidoreductase. Free Radic. Biol. Med. 2014, 77, 121–129. [Google Scholar] [CrossRef][Green Version]
- Huang, Q.; Zhou, H.J.; Zhang, H.; Huang, Y.; Hinojosa-Kirschenbaum, F.; Fan, P.; Yao, L.; Belardinelli, L.; Tellides, G.; Giordano, F.J. Thioredoxin-2 inhibits mitochondrial ROS generation and ASK1 activity to maintain cardiac function. Circulation 2015, 131, 1082. [Google Scholar] [CrossRef]
- Kussmaul, L.; Hirst, J. The mechanism of superoxide production by NADH: Ubiquinone oxidoreductase (complex I) from bovine heart mitochondria. Proc. Natl. Acad. Sci. USA 2006, 103, 7607–7612. [Google Scholar] [CrossRef]
- Klosterman, S.J.; Subbarao, K.V.; Kang, S.; Veronese, P.; Gold, S.E.; Thomma, B.P.; Chen, Z.; Henrissat, B.; Lee, Y.-H.; Park, J. Comparative genomics yields insights into niche adaptation of plant vascular wilt pathogens. PLoS Pathog. 2011, 7, e1002137. [Google Scholar] [CrossRef] [PubMed]
- Alkher, H.; El Hadrami, A.; Rashid, K.; Adam, L.; Daayf, F. Cross-pathogenicity of Verticillium dahliae between potato and sunflower. Eur. J. Plant Pathol. 2009, 124, 505–519. [Google Scholar] [CrossRef]
- Uppal, A.; El Hadrami, A.; Adam, L.; Daayf, F.; Tenuta, M. Pathogenic variability of Verticillium dahliae isolates from potato fields in Manitoba and screening of bacteria for their biocontrol. Can. J. Plant Pathol. 2007, 29, 141–152. [Google Scholar] [CrossRef]
- Zhu, X.; Soliman, A.; Islam, M.R.; Adam, L.R.; Daayf, F. Verticillium dahliae’s Isochorismatase hydrolase is a virulence factor that contributes to interference with potato’s Salicylate and Jasmonate defense signaling. Front. Plant Sci. 2017, 8, 399. [Google Scholar] [CrossRef]
- El-Bebany, A.F.; Henriquez, M.A.; Badawi, M.; Adam, L.R.; El Hadrami, A.; Daayf, F. Induction of putative pathogenicity-related genes in Verticillium dahliae in response to elicitation with potato root extracts. Environ. Exp. Bot. 2011, 72, 251–257. [Google Scholar] [CrossRef]
- Mullins, E.D.; Chen, X.; Romaine, P.; Raina, R.; Geiser, D.; Kang, S. Agrobacterium-mediated transformation of Fusarium oxysporum: An efficient tool for insertional mutagenesis and gene transfer. Phytopathology 2001, 91, 173–180. [Google Scholar] [CrossRef]
- Dobinson, K.F.; Grant, S.J.; Kang, S. Cloning and targeted disruption, via Agrobacterium tumefaciens-mediated transformation, of a trypsin protease gene from the vascular wilt fungus Verticillium dahliae. Curr. Genet. 2004, 45, 104–110. [Google Scholar] [CrossRef] [PubMed]
- Pasquali, M.; Spanu, F.; Scherm, B.; Balmas, V.; Hoffmann, L.; Hammond-Kosack, K.E.; Beyer, M.; Migheli, Q. FcStuA from Fusarium culmorum controls wheat foot and root rot in a toxin dispensable manner. PLoS ONE 2013, 8, e57429. [Google Scholar] [CrossRef]
- Maruthachalam, K.; Klosterman, S.; Kang, S.; Hayes, R.; Subbarao, K. Identification of pathogenicity-related genes in the vascular wilt fungus Verticillium dahliae by Agrobacterium tumefaciens-mediated T-DNA insertional mutagenesis. Mol. Biotechnol. 2011, 49, 209–221. [Google Scholar] [CrossRef] [PubMed]
- Al-Samarrai, T.H.; Schmid, J. A simple method for extraction of fungal genomic DNA. Lett. Appl. Microbiol. 2000, 30, 53–56. [Google Scholar] [CrossRef] [PubMed]
- Elorza, M.V.; Rico, H.; Sentandreu, R. Calcofluor white alters the assembly of chitin fibrils in Saccharomyces cerevisiae and Candida albicans cells. Microbiology 1983, 129, 1577–1582. [Google Scholar] [CrossRef][Green Version]
- Guo, M.; Chen, Y.; Du, Y.; Dong, Y.; Guo, W.; Zhai, S.; Zhang, H.; Dong, S.; Zhang, Z.; Wang, Y. The bZIP transcription factor MoAP1 mediates the oxidative stress response and is critical for pathogenicity of the rice blast fungus Magnaporthe oryzae. PLoS Pathog. 2011, 7, e1001302. [Google Scholar] [CrossRef]
- Lund, R.E. Tables for an Approximate Test for Outliers in Linear Models. Technometrics 1975, 17, 473–476. [Google Scholar] [CrossRef]
- Saxton, A. A macro for converting mean separation output to letter groupings in PROC Mixed. In Proceedings of the 23rd SAS Users Group International, Nashville, TN, USA, 22–25 March 1998; SAS Institute: Cary, NC, USA, 1998; pp. 1243–1246. [Google Scholar]
- Johnson, D.A.; Dung, J.K. Verticillium wilt of potato-the pathogen, disease and management. Can. J. Plant Pathol. 2010, 32, 58–67. [Google Scholar] [CrossRef]
- Tanaka, A.; Takemoto, D.; Hyon, G.S.; Park, P.; Scott, B. NoxA activation by the small GTPase RacA is required to maintain a mutualistic symbiotic association between Epichloë festucae and perennial ryegrass. Mol. Microbiol. 2008, 68, 1165–1178. [Google Scholar] [CrossRef]
- Brun, S.; Malagnac, F.; Bidard, F.; Lalucque, H.; Silar, P. Functions and regulation of the Nox family in the filamentous fungus Podospora anserina: A new role in cellulose degradation. Mol. Microbiol. 2009, 74, 480–496. [Google Scholar] [CrossRef]
- Erincik, B.G. Mating types of Verticillium dahliae isolates from cotton in Aydın Province/Turkey. J. Plant Dis. Prot. 2020, 127, 677–681. [Google Scholar] [CrossRef]

| Primer’s Name | Primer Sequence | Tm (°C) | Accession Number |
|---|---|---|---|
| NoxA-HindIII-F | CCCAAGCTTATGCCTCTCGCCAACCTTT | 59.5 | VDAG_06812 |
| NoxA-IHindIII-R | CCCAAGCTTTCAGAAATGCTCCTTCCAGAAA | 59.3 | VDAG_06812 |
| NoxA-UA-F | CCCTCGCCTGACGGGATT | 62.7 | VDAG_06812 |
| Hph-YG-F [75] | GATGTAGGAGGGCGTGGATATGTCCT | 61.5 | Hph gene |
| Hph-F [76] | TCAGCTTCGATGTAGGAGGG | 55.6 | Hph gene |
| Hph-R [76] | TTCTACACAGCCATCGGTCC | 56.5 | Hph gene |
Publisher’s Note: MDPI stays neutral with regard to jurisdictional claims in published maps and institutional affiliations. |
© 2021 by the authors. Licensee MDPI, Basel, Switzerland. This article is an open access article distributed under the terms and conditions of the Creative Commons Attribution (CC BY) license (https://creativecommons.org/licenses/by/4.0/).
Share and Cite
Zhu, X.; Sayari, M.; Islam, M.R.; Daayf, F. NOXA Is Important for Verticillium dahliae’s Penetration Ability and Virulence. J. Fungi 2021, 7, 814. https://doi.org/10.3390/jof7100814
Zhu X, Sayari M, Islam MR, Daayf F. NOXA Is Important for Verticillium dahliae’s Penetration Ability and Virulence. Journal of Fungi. 2021; 7(10):814. https://doi.org/10.3390/jof7100814
Chicago/Turabian StyleZhu, Xiaohan, Mohammad Sayari, Md. Rashidul Islam, and Fouad Daayf. 2021. "NOXA Is Important for Verticillium dahliae’s Penetration Ability and Virulence" Journal of Fungi 7, no. 10: 814. https://doi.org/10.3390/jof7100814
APA StyleZhu, X., Sayari, M., Islam, M. R., & Daayf, F. (2021). NOXA Is Important for Verticillium dahliae’s Penetration Ability and Virulence. Journal of Fungi, 7(10), 814. https://doi.org/10.3390/jof7100814

